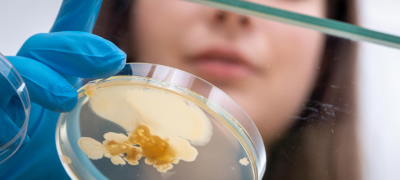
Что нужно знать о микрофлоре кишечника и как наладить пищеварение малыша?

Полный доступ для зарегистрированных пользователей
Платформа по детской нутрициологии в помощь практикующему врачу-педиатру
Полный доступ для зарегистрированных пользователей
Полный доступ для зарегистрированных пользователей
Платформа по детской нутрициологии
в помощь практикующему врачу
Каждый год все больше детей рождается в результате кесарева сечения, и в ближайшем будущем тенденция вряд ли изменится. Возникает вопрос: как минимизировать риски для здоровья детей сейчас и в будущем? Нам нужно пон...
Развернуть
Каждый год все больше детей рождается в результате кесарева сечения, и в ближайшем будущем тенденция вряд ли изменится. Возникает вопрос: как минимизировать риски для здоровья детей сейчас и в будущем? Нам нужно понять, как специфические особенности микробиоты кишечника влияют на развитие и что можно сделать с самого начала жизни ребенка для его здорового и гармоничного развития. Откройте для себя эффективные методы улучшения здоровья этих детей уже сегодня.
Свернуть
Полезная кишечная микрофлора очень важна для здоровья человека, так как обеспечивает иммунитет, и о ней надо постоянно заботиться.

Проверьте свои знания
Попробуйте правильно ответить на три вопроса. Когда закончится таймер, ответ появится автоматически.
Начать

Nestogen® — на страже здоровья кишечника и развития головного мозга
С ингредиентами, способствующими профилактике ФРП и развитию головного мозга.
К продукту!
Пройти квиз еще раз

Алгоритм ведения детей с аллергией к белкам коровьего молока
Для диетотерапии аллергии к белкам коровьего молока у ребенка разработано множество рекомендаций — как международных, так и российских.
Однако, они не дают понимания, как оценить успешность проводимой диетотерапии, а также на какие критерии ориентироваться для максимально безопасной смены этапов и введения в рацион новых продуктов.
Предлагаем вам алгоритм ведения ребёнка с АБКМ, который содержит новые конкретные маркеры для оценки эффективности диетотерапии.Выберите степень течения:
Легкое, среднетяжелое, тяжелое течение
Очень тяжелое течение, анафилаксия
Диагностика и лечение
Легкое, среднетяжелое, тяжелое течение

Научно-образовательный квест для педиатров
Какой совет необходимо зазубрить маме по образу жизни ребенка для снижения рисков заболеваний?

- Цель квеста: узнать все секреты снижения риска инфекций и проверить свои знания. Правильно отвечая на вопросы профессора, Вы увидите снижение температуры на градуснике. В каждой части квеста будет рассмотрено 7 интересных вопросов.
- Каждый правильный ответ снижает температуру на градуснике на 0,4 градуса, а ложный — повышает температуру на 0,2 градуса. Используя подсказку профессора, вы повышаете температуру на 0,2 градуса.
Начать
Информация на этом сайте предназначена исключительно для медицинских работников и применима только к продуктам, которые продаются в Российской Федерации. Если вы — медицинский работник, отметьте «Я согласен/согласна» и нажмите «Продолжить», чтобы получить доступ к материалам. Если вы являетесь будущими родителями или родителями и ищете информацию, пожалуйста, перейдите на наш сайт https://www.nestlebaby.ru.
Важное замечание и заявление
Посещая этот сайт и используя его материалы, вы подтверждаете, что являетесь практикующим медицинским работником. Содержание этого сайта предназначено только для информационных и образовательных целей. Nestlé поддерживает и продвигает рекомендацию Всемирной организации здравоохранения об исключительно грудном вскармливании в первые 6 месяцев с последующим введением полноценного прикорма при продолжении грудного вскармливания до двух лет и более.
Показать полностью
Наш сайт в формате приложения всегда под рукой!
Нажмите на кнопку ниже и запустите установку приложения на следующей странице. При первом входе приложение запросит у вас разрешение на уведомления. Пожалуйста, нажмите «Да», если разрешаете приложению Nestle Baby&me Medical отправлять рекламные и информационные уведомления.
Начать
Установить приложение Nestlé Baby&me Medical
Приложение запросит у вас разрешение на уведомления. Пожалуйста, нажмите «Да», если разрешаете приложению Nestle Baby&me Medical отправлять рекламные и информационные уведомления.
Хорошо
Ваш браузер не поддерживает автоматическую установку PWA приложений или приложение уже установлено. Откройте его из списка приложений или:
- 1. Нажмите на значок «Поделиться», он находится рядом с адресной строкой.
- 2. Выберите «Добавить на главный экран» и нажмите «Добавить».
НОВЫЙ ЧЕК-ЛИСТ
Осмотр здорового ребёнка